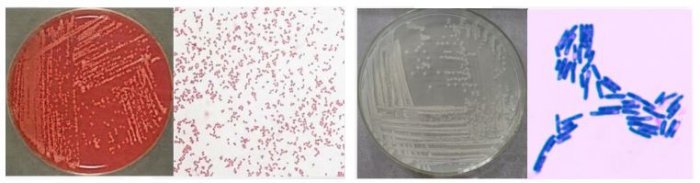

Risen Petroleum Equipment Co., Ltd.
RisenPetro - Model Bio01 -Microorganism (Microbe) / Bioremediation of Oily Sludge
Cooperating with the Institute of Microbiology at a top university in China, we have accumulated years of experience in studying and applying microorganisms in the disposal and treatment of oily sludge and oil-based drill cuttings.
Most popular related searches
oil sludge
drill cuttings
total petroleum hydrocarbons
oil drill cuttings
oil sludge disposal
sludge oil
drilling mud
hydrocarbons sludge
bioremediation microbiology
hydrocarbons degradation
Our microorganisms can effectively and efficiencly remove and degrade hydrocarbons in oily sludge and drill cuttings, reducing the TPH (total petroleum hydrocarbons) from above 10% to at least 0.2%, which is the newest permissible limit defined by the environmental authority in Shaanxi Province, where Risen Petrol locates.
Within 90 days, the oily sludge or drill cuttings can change from … to…:


